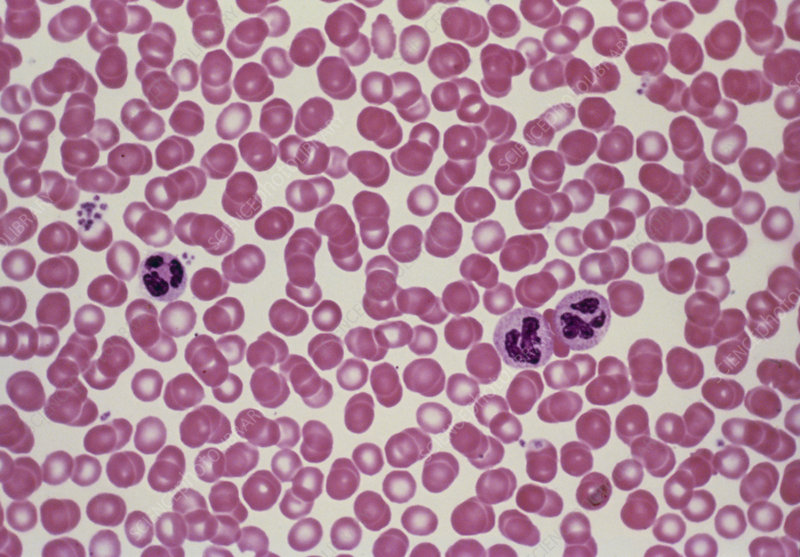

Welcome to immunology.
In this course, you will learn about the immune system and how it works as well as it's disorders. You will also learn the applications in various laboratory techniques.
- Manager, Teacher: Christopher Too
- Teacher: owuor Emma
- Student: chepleting adela
- Student: ochieng anyango
- Student: mercyline awuor
- Student: mitchel ayako (112654m25)
- Student: esther chamtai
- Student: maurine chebet
- Student: winnie chemitei
- Student: joy chepkoech
- Student: daisy chepngeno
- Student: jemwetch cheruiyot
- Student: jepleting correthy
- Student: ronoh elias
- Student: kipchichir faith
- Student: mariam jamilah (113111j25)
- Student: fresky jebet
- Student: lydia jebet
- Student: justine jemutai
- Student: kimaiyo jepkoech
- Student: sheilla jepkoech
- Student: kurui ily jerono
- Student: staycy j jerono
- Student: kimuta joyce
- Student: sharon kemboi
- Student: caren epchumba kimutai
- Student: belinda kiprop
- Student: sharonjeptoo kipyeo
- Student: hildahjepkorir koech
- Student: yvonne koech
- Student: cherono lavender
- Student: chepngno lynn
- Student: jelaga marion
- Student: annah nyabuto
- Student: faith odhiambo
- Student: donvine omwony
- Student: nancy opete
- Student: shelly peace
- Student: lilian wafula